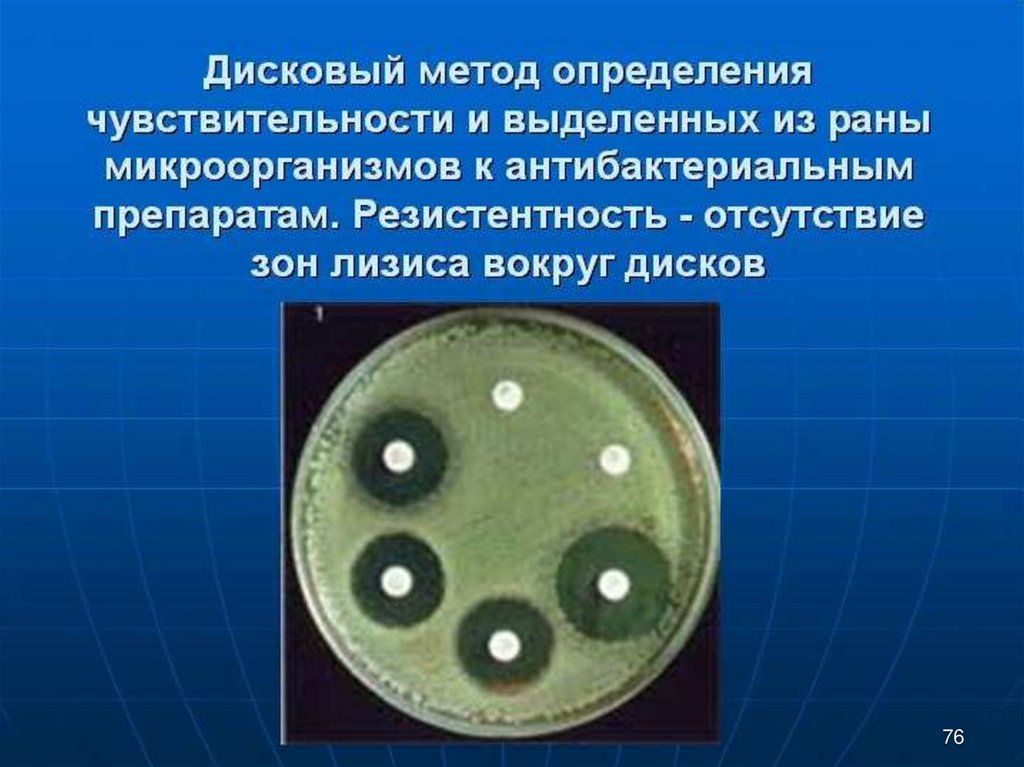

Похожие презентации:
Асептика и антисептика. Кровотечения
1.
Медицинская академия им. С.И. ГеоргиевскогоКАФЕДРА ОБЩЕЙ ХИРУРГИИ
ЛЕКЦИЯ №1
АСЕПТИКА И АНТИСЕПТИКА
КРОВОТЕЧЕНИЯ
ЛЕКТОР: Татарчук П.А.
СИМФЕРОПОЛЬ 2022
06.12.2022 14:13
1
2.
06.12.2022 14:132
3.
История антисептики началась еще в незапамятныевремена. В трудах врачей древнего Египта и Греции можно
встретить упоминания об их использовании. Однако
никакого научного обоснования тогда еще не было. Только
с середины девятнадцатого столетия антисептик стал
целенаправленно и осмысленно применяться как
вещество, способное предупредить процессы гниения. В
то время хирурги провели множество успешных операций.
Однако серьезные проблемы по-прежнему возникали при
лечении ран. Даже несложные операции могли
закончиться летальным исходом. Если обратиться к
статистике, то каждый шестой пациент умирал после или
во время хирургического вмешательства.
06.12.2022 14:13
3
4.
Игнац ФилиппЗеммельвайс
06.12.2022 14:13
В 1847 г., пытаясь понять причины
послеродовой горячки (сепсиса) у
многих рожениц — и, в частности, того
факта, что смертность при родах в
больнице (30—40 и даже 50 %)
намного превосходила смертность при
домашних родах, — Земмельвайс
предположил, что инфекцию приносят
из инфекционного и
патологоанатомического отделений
больницы. Врачи в то время много
практиковали в прозекторской, и
принимать роды часто прибегали
прямо от трупа, вытерев руки
носовыми платками. Земмельвайс
обязал персонал больницы перед
манипуляциями с беременными и
роженицами обеззараживать руки
окунанием их в раствор хлорной
извести. Благодаря этому смертность
среди женщин и новорожденных упала
более чем в 7 раз — с 18 до 2,5 %
4
5.
Научно обосновать понятиеантисептиков стало возможным
только после публикации работ
доктора Л. Пастера. Именно он в
1863 году показал, что за
процессами гниения и брожения
стоят микроорганизмы. Для
хирургии в данной области
светилом стал Джозеф Листер.
Англичанин, заложивший основы
антисептики. В 1865 году он первым
заявил: «Ничего, что не
обеззаражено, не должно
прикасаться к ране». Именно
Листер придумал, как при помощи
химических методов бороться с
раневой инфекцией. Он разработал
знаменитую повязку, смоченную в
карболовой кислоте.
06.12.2022 14:13
Джозеф Листер
5
6.
Профессор пришел к выводу, что нагноение ранпроисходит из-за того, что в них попадают
бактерии. Он впервые дал научное обоснование
такому явлению, как хирургическая инфекция, и
придумал способы борьбы с ней. Главным
антисептиком являлась карболовая кислота (2-5%ный водный, масляной или спиртовой раствор)..
Так, хирурги смазывали руки, обрабатывали
инструменты, перевязочные и шовные материалы,
все операционное помещение.
06.12.2022 14:13
6
7.
Огромное значение Листер придавал воздуху вхирургическом помещении. Он считал, что это прямой
источник микробов. Поэтому комнату также обрабатывали
карболовой кислотой при помощи специального распылителя.
06.12.2022 14:13
7
8.
06.12.2022 14:13Н.И. Пирогов во время Крымской
войны
(1853-1856) писал: «...можно
смело утверждать, что большая
часть раненых умирает не
столько от самих повреждений,
сколько от госпитальной заразы...
От нас недалеко то время, когда
тщательное изучение
травматических и госпитальных
миазм даст хирургам другое
направление».
Н.И. Пирогов считал, что зараза
(«миазмы») передаётся через
руки, бельё, матрацы,
перевязочный материал, и
рекомендовал в связи с этим
гигиенические мероприятия.
Он применял для лечения ран
спирт, йод, нитрат серебра,
способные уничтожить «миазмы».
8
9.
Бергманн совместно сосвоим учеником
Шиммельбушем одним из
первых внедрил в
мировую практику
обработку хирургического
инструментария с
помощью специально
созданной паровой
машины в 1885 году.
В 1890 г. они доложили об
этом методе асептики на X
Международном конгрессе
врачей в Берлине.
06.12.2022 14:13
9
10.
06.12.2022 14:1310
11.
06.12.2022 14:1311
12.
06.12.2022 14:1312
13.
МЕТОДЫ БОРЬБЫ С ИНФЕКЦИЕЙ В ВОЗДУХЕ1.Ношение масок
2.Бактерицидные лампы
3.Вентиляция
4.Личная гигиена больных и медицинского
персонала
5.Контроль отсутствия простудных и
гнойничковых заболеваний (1 раз в 3 месяца)
06.12.2022 14:13
13
14.
ПРОФИЛАКТИКА КОНТАКТНОЙ ИНФЕКЦИИВсе, что соприкасается с раной, должно быть
стерильно:
•хирургические инструменты
•перевязочный материал и хирургическое белье,
руки хирурга
•операционное поле (кожа самого больного).
06.12.2022 14:13
14
15.
06.12.2022 14:1315
16.
Стерилизация – это комплекс мероприятий,который обеспечивает гибель на стерилизуемых
изделиях вегетативных и споровых форм
микроорганизмов.
Ей подлежат все изделия, соприкасающиеся с
раневой поверхностью, кровью, слизистыми,
лекарственным препаратами.
Выбор метода стерилизации зависит от
материала, из которого изготовлен инструмент.
06.12.2022 14:13
16
17.
Физические методы стерилизации:•обжигание и кипячение;
•стерилизация паром под давлением
(автоклавирование);
•стерилизация горячим воздухом;
•лучевая стерилизация.
Химические методы стерилизации:
•газовая стерилизация;
•стерилизация растворами химических препаратов.
06.12.2022 14:13
17
18.
• СТЕРИЛИЗАЦИЯ ХИРУРГИЧЕСКИХ ИНСТРУМЕНТОВ• Включает 2 этапа:
• предстерилизационную обработку (обеззараживание, мытьё и
высушивание);
• непосредственно стерилизацию.
Обеззараживание
Непосредственно после использования инструменты погружаются в емкость с
дезинфицирующими средствами - 3% раствором хлорамина (экспозиция 40-60
минуту) или 6% раствором перекиси водорода (экспозиция 90 минут). После
обеззараживания инструменты промываются проточной водой.
В настоящее время методики обеззараживания упрощаются в связи с
появлением современных дезинфектантов (прим. Аминаз+ 0,2% , обработка
производится в 2 емкостях. В первой ополаскивание, удаление видимых
загрязнений, в второй экспозиция 30 мин. Далее промывание под проточной
водой и сушка. Высушивание может осуществляться естественным путем или
в сухожаровом шкафу при 80°С в течение 30 минут.
06.12.2022 14:13
18
19.
Контроль качества предстерилизационнойобработки
Положительные пробы на скрытую кровь:
азопирам(универсальная) – фиолетовое
переходит в розово- сиреневое
амидопирин
- сине-зеленое
бензидин
- ярко-зеленое
ортотолуидин
- сине-зеленое
Проба на остатки моющего средства
фенолфталеином – розовое окрашивание
06.12.2022 14:13
19
20.
• Стерилизация паром под давлениемпроводится в специальных приборах – автоклавах. Принцип его
работы основан на повышении температуры закипания воды при
повышении давления. При давлении 1,1 атм. достигается
температура 120˚С, при 2 атм. – 132,9˚С. Это позволяет добиться
более полного удаления микробов и их спор.
06.12.2022 14:13
20
21.
• Стерилизацияпаром
Существует три
основных
режима
стерилизации:
• при давлении 1,1
атмосферы—1час;
• при давлении 1,5
атмосферы—45
минут;
• при давлении 2
атмосферы — 30
минут.
06.12.2022 14:13
21
22.
• Стерилизация горячим воздухом осуществляется вспециальных аппаратах сухожаровых шкафахстерилизаторах. Вначале инструменты высушивают в
течение 30 минут при температуре 80°С с
приоткрытой дверцей. Стерилизация осуществляется
при закрытой дверце в течение 1 часа при
температуре 180°С.
06.12.2022 14:13
22
23.
• Установка дляпроизводственной
стерилизации
Лучевая стерилизация является
наиболее эффективным
методом и осуществляется в
заводских условиях при
помощи γ-излучения.
Этот способ применяется в
основном для стерилизации
шовного материала и
одноразовых инструментов
(шприцы, иглы, перчатки,
гинекологические зеркала и
др.).
06.12.2022 14:13
23
24.
•Газовая стерилизация осуществляется в специальныхгерметичных камерах парами формалина или окиси
этилена и продолжается 6-48 часов. Отрицательное
влияние на качество инструментария здесь минимально,
в связи с чем способ используют прежде всего для
стерилизации оптических, особо точных и
дорогостоящих инструментов
•Стерилизация растворами антисептиков относится к
холодным способам стерилизации и не приводит к
затуплению режущих хирургических инструментов. Для
стерилизации в настоящее время используют
современные средства (прим. Альдезин-ультра 5%)
инструменты считаются стерильными через 15 минут
экспозиции. Он же применим для стерилизации
оптических инструментов.
06.12.2022 14:13
24
25.
Хирургические инструменты можно условно разделить натри группы:
металлические (режущие и нережущие);
резиновые и пластмассовые;
оптические.
• Режущие металлические инструменты
• Стерилизуются холодным химическим способом с применением
растворов антисептиков.
• Реже применяется стерилизация в сухожаровом шкафу.
• Самыми лучшими способами являются газовая стерилизация и
лучевая стерилизация в заводских условиях.
• Резиновые и пластмассовые инструменты
• Основным методом стерилизации резиновых изделий является
автоклавирование. В последнее время используются
одноразовые перчатки, подвергшиеся лучевой заводской
стерилизации.
06.12.2022 14:13
25
26.
• СТЕРИЛИЗАЦИЯ ПЕРЕВЯЗОЧНОГО МАТЕРИАЛА И БЕЛЬЯ• К перевязочному материалу относятся
марлевые шарики, тампоны, салфетки, бинты,
турунды, ватно-марлевые тампоны.
• Перевязочный материал повторно не
используется и после применения сжигается.
• К операционному белью относятся
хирургические халаты, простыни, полотенца,
пеленки.
• Перевязочный материал и белье укладывают в
биксы и стерилизуют автоклавированием при
стандартных режимах.
06.12.2022 14:13
26
27.
• Бикс ШиммельбушаСуществуют три
основных вида
укладки бикса:
.
универсальная;
целенаправленная;
видовая.
06.12.2022 14:13
27
28.
•Простерилизованные материалы могут храниться в:•бикс Шиммельбуша (3 суток)
• пакет для стерилизации
• креппированная бумага (3 суток)
• бумажная упаковка с полоской термоклея и
индикатором стерилизации (60 суток)
• комбинированная упаковка с одной стороны
ламинированная бумага, с другой – полиэтилен (1 год)
Для снижения риска вторичного
обсеменения микроорганизмами
медицинских металлических инструментов, простерилизованных в
неупакованном виде, при их временном хранении до применения
используют специальные камеры,
оснащенные ультрафиолетовыми
лампами.
06.12.2022 14:13
28
29.
• СПОСОБЫ КОНТРОЛЯ СТЕРИЛЬНОСТИ• физический способ – регистрация факта перехода вещества из
одного физического состояния в другое;
• химический способ – регистрация факта химической реакции;
• биологический способ – регистрация факта отсутствия роста
микроорганизмов при посеве.
• В автоклаве применяют следующие
• вещества:
• бензойная кислота (tпл=120˚С);
• резорцин (119˚С);
• антипирин (110˚С).
• В сухожаровом шкафу
• аскорбиновая кислота(190˚С);
• янтарная кислота(180-184˚С);
• тиомочевина(180˚С).
06.12.2022 14:13
29
30.
На руках людей различают микрофлору двойногопроисхождения:
- преходящая, легко смываемая;
- постоянная, гнездящаяся в складках и порах кожи,
постоянно живущая и размножающаяся на коже рук.
Задача обработки рук двойная — уничтожение микробов на
поверхности кожи и создание условий, препятствующих
выходу микробов из глубоких слоев кожи на поверхность.
Поэтому методы обработки рук хирурга слагаются из 3-х
составляющих:
- механической очистки;
- обработки антисептическими растворами;
- дублении кожи или покрытии ее тонкой пленкой.
При всех методах мытья рук обязательно надевание
резиновых перчаток.
06.12.2022 14:13
30
31.
06.12.2022 14:1331
32.
06.12.2022 14:1332
33.
06.12.2022 14:1333
34.
06.12.2022 14:1334
35.
06.12.2022 14:1335
36.
06.12.2022 14:1336
37.
06.12.2022 14:1337
38.
06.12.2022 14:1338
39.
06.12.2022 14:1339
40.
06.12.2022 14:1340
41.
06.12.2022 14:1341
42.
В оперблоке выделяют 4 зоны стерильности:зона абсолютной стерильности - около
операционного и сестринского стола;
зона относительной стерильности – вся
остальная операционная;
зона ограниченного режима –
предоперационная;
зона общебольничного режима
(нестерильная) – подсобные помещения
06.12.2022 14:13
42
43.
• Попадание воздуха, содержащего высоко вирулентную флору из палаты,коридора хирургического отделения в операционную совершенно не
допустимо. Это обеспечивается приточным методом вентиляции: в
операционной создается несколько повышенное атмосферное давление, 0,2 0,3 атм. Поэтому воздух будет поступать из операционной в коридор
хирургического отделения и в палаты, а не наоборот. Это самый важный
принцип предотвращения воздушно- капельной инфекции!
06.12.2022 14:13
43
44.
06.12.2022 14:1344
45.
Внутрибольничная инфекцияПроблема ВБИ остается одной из острых в
современном здравоохранении.
ВБИ имеет большую
медицинскую значимость
•Удлинение времени пребывания больных в стационаре
•Рост летальности
•Материальные потери ЛПУ
социальную значимость
•Отключение больного от семьи и трудовой деятельности
•Инвалидизация больного
•Летальные исходы
06.12.2022 14:13
45
46.
Наиболее распространенныеВБИ
Инфекции мочевыделительной системы
Гнойно-воспалительные инфекции
Инфекции дыхательных путей
Инфекции кожных покровов
06.12.2022 14:13
46
47.
Основные возбудители ВБИ:Грамположительные
палочки
Стафилококк, стрептококк,
энтерококк
Грамотрицательные
палочки
Энтеробактерии,
Синегнойная палочка
Условно-патогенные
и патогенные грибы
Плесневые грибы
Дрожжеподобные грибы
Возбудители микозов
Вирусы
06.12.2022 14:13
Возбудители простого герпеса, ветряной оспы
Аденовирусы
Вирусы гриппа и парагриппа
Энтеровирусы
Возбудители вирусных гепатитов
47
48.
Причиной возникновения ВБИ могут быть:Зараженный инструментарий
Медицинская аппаратура
Постельные принадлежности
Матрацы
Кровати
Поверхности кранов, раковин
Контаминированные растворы антисептиков,
антибиотиков, других лекарственных препаратов
Предметы ухода за больными
Перевязочный и шовный материал
Дренажи
Кровь и кровезамещающие растворы
Спецодежда
Волосы
и руки больных и медперсонала
06.12.2022 14:13
48
49.
Основные источники госпитальных инфекций.Источник
Роль источника в распространении
Больные
Основной источник; роль в распространении при различных
нозологических формах и в различных стационарах варьирует
Носители
Имеет большое значение в распространении стафилококковых
инфекций, гепатитов B, C и D, сальмонеллез, шигеллез и др.
Медицинские
работники
Чаще бессимптомные носители преимущественно "госпитальных"
штаммов; играют важную роль в распространении возбудителей
респираторных инфекций (пневмоний, бронхитов и ОРВИ). Частота
носительства могу достигать 50%.
Большого значения не имеют, могут быть носителями стрептококков,
Лица,
привлекаемые
к стафилококков, энтеро - и камбилобактерий, возбудителей венерических
уходу за больными болезней, ротавирусов, цитомегаловирусов и прочих герпетовирусов,
возбудителей гепатитов и дифтерии, пневмоцист.
Посетители,
навещающие
больных
06.12.2022 14:13
Роль очень ограничена, могу быть
энтеробактерий либо болеть ОРВИ.
носителями стафилококков,
49
50.
Наиболее опасные с точки зрения передачи ВБИследующие мероприятия:
1. Диагностические
2. Лечебные
06.12.2022 14:13
•Забор крови
•Зондирование желудка,
двенадцатиперстной кишки
•Эндоскопии
•Пункции
•Биопсии
•Венесекция
•Мануальные исследования
•Трансфузии (крови, сыворотки, плазмы)
•Инъекции
•Операции
•Интубация
•Ингаляционный наркоз
•ИВЛ
•Катетеризация сосудов, мочевого пузыря
•Гемодиализ
•Ингаляции лечебных аэрозолей
•Трансплантация тканей и органов
50
51.
Пути передачи ВБИ:Воздушно-капельный, воздушно-пылевой
Контактный, предметно-бытовой,
гемоконтактный
Пищевой, водный
Артифициальный (искусственный) или
медицинский (через руки медперсонала,
инструменты, перевязочный материал
06.12.2022 14:13
51
52.
Особенности ВБИ+ возбудители устойчивы к основным
антибиотикам и антисептикам;
+ возбудители условно-патогенные организмы
(чаще стафилококк, клипсиела, кишечная
палочка протей и др.);
+ возникает чаще у ослабленных больных;
+ массовое поражение одним штаммом м/с и с
одинаковой клиникой.
06.12.2022 14:13
52
53.
06.12.2022 14:1353
54.
06.12.2022 14:1354
55.
06.12.2022 14:1355
56.
Механическая антисептикаОснова механической антисептики удаление из инфицированной, гнойной раны,гнойного очага нежизнеспособных тканей,
гноя, фибрина, являющихся средой обитания
и питания микробной флоры. Удаление
девитализированных тканей, хотя и является
не прямым, а опосредованным действием на
микрофлору, способствует стерилизации
раны.
Вариантом может быть первичная
хирургическая обработка.
06.12.2022 14:13
56
57.
Механическая антисептика06.12.2022 14:13
57
58.
Физическая антисептикаМетоды физической антисептики основанына использовании законов капиллярности,
гигроскопичности, диффузии, осмоса,
принципа сифона, воздействия энергии
лазера, ультразвука.
Пример – дренирование ран, гнойных очагов
(абсцессов, эмпием) с созданием условий для
оттока раневого отделяемого во внешнюю
среду (в повязку, специальную посуду с
антисептическими растворами).
06.12.2022 14:13
58
59.
Физическая антисептика06.12.2022 14:13
59
60.
Химическая антисептикаХимические антисептики - вещества, используемые
для местного применения, позволяющие создать
высокую концентрацию антибактериального
препарата непосредственно в очаге гнойного
воспаления. Препараты более устойчивы к
воздействию продуктов воспаления или некроза
тканей, чем антибиотики. Антибактериальную
активность антисептиков повышает использование
других средств и методов антисептики - физических
факторов (дренирования, УЗ, энергии лазера,
плазмы), некролитических-протеолитических
ферментов, гипохлорита натрия, биологических
(бактериофагов).
06.12.2022 14:13
60
61.
Механизм действия антисептиковбактериостатическое –вызывает нарушение
констант метаболических процессов в
микробных клетках, блокирует клеточное
деление;
бактерицидное – приводит к разрушению
протоплазмы микроорганизмов.
06.12.2022 14:13
61
62.
06.12.2022 14:1362
63.
Группы химических антисептиков• Группа галоидов
• Соли тяжелых
металлов
• Спирты
• Альдегиды
• Фенолы
• Красители
• Кислоты
• Щелочи
• Окислители
• Детергенты
06.12.2022 14:13
• Производные
нитрофурана
• Производные 8оксихинолина
• Производные
хиноксалина
• Производные
нитроимидазола
• Дегти, смолы
• Антисептики
растительного
происхождения
• Сульфаниламиды
63
64.
Биологическая антисептикаРазделяется на два вида:
биологическая антисептика прямого действия
(вещества биологического происхождения,
непосредственно воздействующие на
микроорганизмы):
1.антибиотики
2.бактериофаги
3.антитоксины
биологическая антисептика опосредованного
действия (вещества и методы различного
происхождения, оказывающие воздействие на
организм больного, стимулирующие его способности
по уничтожению микроорганизмов): переливание
крови, плазмы и иммуноглобулинов.
06.12.2022 14:13
64
65.
Биологические антисептикиПрямого
действия
антибиотики
Протеолитические
ферменты
Местные
антисептики
Неспецифическая
стимуляция
иммунитета
УФО крови,Кварц
Лазерное облучение
Переливание крови
Средства,
стимулирующие
специфический
иммунитет:
Опосредованного
действия
Средства
пассивной
иммунизации
•Сыворотки
•γ-глобулины
столбнячный,
стафилококковый
анатоксины
06.12.2022 14:13
65
66.
БиохирургияИспользование личинок мух
для очищения и заживления
ран. Известно с 1931г.
Плюсы:
oБыстрое и полное очищение ран
oБактериостатический эффект
oСнижение вероятности нагноения
oПовышение РН раны
oПротеолитический эффект
Минусы:
oВозможные болевые ощущения
oЭстетический и психологический дискомфорт
06.12.2022 14:13
66
67.
Протеолитические ферментыСами не уничтожают микроорганизмы, но лизируют
некротические ткани, фибрин, разжижают гнойный
экссудат.
• Трипсин, химотрипсин, химопсин - препараты
животного происхождения, их получают из поджелудочной железы крупного рогатого скота.
• Террилитин - продукт жизнедеятельности
плесневого грибка Aspergillis lerricola
• Ируксол - мазь, в состав которой входит фермент
клостридилпептидаза и антибиотик левомицетин.
• Стрептокиназа, батериальная коллагеназа –
препарараты микробного происхождения.
06.12.2022 14:13
67
68.
Антибиотики•В 1929 году англичанин Флеминг вырастил
грибок Penicillinum notatum, способный
уничтожать стрепто- и стафиликокки.
•В 1940 году группа ученых Оксфордского
университета во главе с Говардом Флори назвала
это вещество ПЕНИЦИЛЛИНОМ
06.12.2022 14:13
68
69.
06.12.2022 14:1369
70.
06.12.2022 14:1370
71.
•Пенициллины (ингибируют синтез клеточнойстенки микроорганизма).
• Цефалоспорины (нарушают синтез клеточной
стенки МО, широкий спектр, нефротоксичны в
высоких дозах):
• 1-е поколение: цепорин, цефалексин. цефазолин,
цефамезин. кефзол,
• 2-е поколение: цефамандол, цефметазол,
цефокситин, цефаклор, цефуроксим, цефотетан,
• 3-е поколение: цефтриаксон, цефотаксим,
цефиксим, пефтибутен, пефпирамид.
цефтазидим,
• 4-е поколение: цефпиром (кейтен).
06.12.2022 14:13
71
72.
• Стрептомицины (подавляют функцию рибосомМО, широкий спектр, ото -, нефро-.
гепатотоксичны, угнетают гемопоэз).
• Тетрациклины (гепатотоксичны; подавляют
функцию рибосом, широкий спектр): тетрациклин,
метациклин, доксициклин.
• Макролиды (нарушают синтез белка в МО,
гепатотоксичны возможно нарушение функции
ЖКТ).
• Аминогликозиды (ото- и нефротоксичны):
канамицин, гентамицин, тобрамицин, сизомицин,
полусинтетические: амикацин, нетромицин.
06.12.2022 14:13
72
73.
•Левомицетины (нарушают синтез белка в МО,угнетают гемопоэз): левомицетин.
• Рифампицины (нарушают синтез белка в МО,
вызывают гиперкоагуляцию, гепатотоксичны):
рифампицин.
• Противогрибковые антибиотики: леворин,
нистатин, полимиксин В.
• Линкозамины: линкомицин, клиндамицин
06.12.2022 14:13
73
74.
•Фторхинолоны (подавляют ДНК-гидразуМО,широкий спектр действия):
• 3-е поколение: офлоксацин;
ципрофлоксацин.
• 4-е поколение: левофлоксацин;
флероксацин;
тосуфлоксацин.
•Карбапенемы (нарушают синтез клеточной
стенки МО, широкий спектр): имипенем,
меропенем.
•Гликопептиды: ванкомицин.
06.12.2022 14:13
74
75.
06.12.2022 14:1375
76.
06.12.2022 14:1376
77.
06.12.2022 14:1377
78.
06.12.2022 14:1378
79.
06.12.2022 14:1379
80.
06.12.2022 14:1380
81.
06.12.2022 14:1381
82.
06.12.2022 14:1382
83.
Кафедра общей хирургииКровотечения и кровопотеря.
Методы остановки
кровотечения
83
84.
Кровотечение (haemorrhagia)истечение
(выхождение)
крови
из
просвета
кровеносного сосуда вследствие его повреждения или
нарушения проницаемости его стенки.
Кровотечение — одно из самых тяжелых осложнений
различных заболеваний и повреждений. Кровотечения
представляют непосредственную угрозу жизни
больного и всегда требуют незамедлительных
действий. И от того, насколько грамотными будут эти
действия, зависит судьба человека.
84
85.
Собственно кровотечение – кровь активнопоступает из сосуда (сосудов) во внешнюю
среду, полый орган, полости организма.
Кровоизлияние – кровь, выходя из просвета
сосуда, пропитывает окружающие ткани.
Гематома
– излившаяся кровь вызывает
расслоение тканей, раздвигание органов, в
результате чего образуется искусственная
полость, заполненная кровью
85
86.
Классификация кровотеченийПо причине возникновения
Механическая
(постравматические)
в
результате травм и ранений
Аррозия – в следствие разъедания стенки
сосуда патологическим (некроз) процессом (язва
желудка, распадающаяся опухоль, гнойное
расплавление тканей)
Диапедез – повышение проницаемости стенок
сосудов –при болезнях крови, авитаминозах
(цинга), сепсисе, геморрагическом васкулите
Изменения
свертывающей
и
противосвертывающей системы крови.
86
87.
Кровотечение при геморрагическом васкулите(диапедез)
87
88.
Анатомическая классификация:Артериальное
кровотечение – кровь истекает
быстро, под давлением, часто пульсирующей
струей, ярко-алого цвета
Венозное – постоянное истечение крови вишневого
цвета. Скорость кровопотери ниже, чем при
артериальном кровотечении.
Капиллярное – смешанное, происходит истечение
артериальной и венозной крови. При этом вся
раневая поверхность после удаления излившейся
крови вновь покрывается кровью.
Паренхиматозное – возникает при повреждении
паренхиматозных органов: печени, селезенки,
почек, легких.
88
89.
Повреждения печени, поджелудочнойжелезы и селезенки
(паренхиматозное кровотечение)
89
90.
По отношению к внешней среде:Наружное – кровь вытекает во внешнюю среду
наружные явные
наружные
скрытые
–
кровотечения
без
клинических признаков, кровь даже в измененном
виде через какой-то промежуток времени появляется
снаружи (melena, haemobilia, haematuria)
Внутреннее
– кровь поступает в просвет полых
органов, в ткани ли внутренние полости организма не
сообщающиеся со внешней средой. (haemoperitoneum,
haemothorax, haemopericardium)
90
91.
НАРУЖНОЕ СКРЫТОЕ КРОВОТЕЧЕНИЕРвотные массы цвета «кофейной гущи»
Черный жидкий стул – мелена.
91
92.
По времени возникновения:Первичные
–
связаны
непосредственно
с
повреждением сосуда во время травмы. Появляется
сразу или в первые часы после повреждения.
Вторичные:
Вторичные
ранние (несколько часов – 4-5 суток
после повреждения) – связаны с соскальзыванием с
сосуда лигатуры или с вымыванием из сосуда тромба;
Вторичные поздние, или аррозивные (более 4-5
суток после повреждения) – связаны с деструкцией
сосудистой стенки в результате развития в ране
инфекционного процесса.
92
93.
Классификация кровопотериПо течению:
Острое – истечение крови
короткий времени;
Хроническое
–происходит
малыми порциями.
возникает
в
постепенно,
По степени тяжести кровопотери:
Легкая – потеря до 10% ОЦК (до 500 мл)
Средняя – потеря 10-20% ОЦК (500-1000 мл)
Тяжелая – потеря 21-30% ОЦК (1000-1500 мл)
Массивная кровопотеря –более 30% ОЦК
(более 1500 мл)
93
94.
Компенсаторно-приспособительныемеханизмы при острой кровопотере
Веноспазм
Приток тканевой жидкости
Тахикардия
Олигурия
Гипервентиляция
Периферический артериолоспазм
94
95.
Патогенез кровопотериВсе компенсаторно-приспособительные реакции
организма при острой кровопотере направлены на
поддержание центральной гемодинамики и сохранение
нормального уровня АД. Для этого в первую очередь
организм старается ликвидировать возникшее в
результате кровопотери опасное для центральной
гемодинамики несоответствие емкости сосудистого
русла сниженному ОЦК.
Это осуществляется двумя путями:
уменьшением емкости сосудистого русла за счет
спазма сосудов,
восполнением дефицита ОЦК за счет депонированной
крови из межтканевой жидкости.
95
96.
Уменьшением емкости сосудистого руслаза счет спазма сосудов (патогенез)
В результате повышения активности
симпатико-адреналовой системы первым на
кровопотерю реагирует венозное русло, в
котором находится 65-70% всей
циркулирующей крови. Венозный спазм
достигает максимума уже в первые минуты
после кровотечения и может длиться много
часов. Сужение венозного русла быстро
приводит в соответствие емкость сосудистого
русла оставшемуся объему крови. При этом
венозный возврат крови к сердцу ускоряется, а
сердечный выброс остается нормальным и
кровоснабжение органов и тканей практически
не изменяется. Этот защитный механизм легко
компенсирует потерю до 10% ОЦК.
96
97.
При потере более 10-15% ОЦК этот защитныймеханизм уже не справляется с компенсацией и
не может обеспечить достаточный венозный
возврат крови к сердцу. Возникает «синдром
малого выброса», приводящий к снижению
кровоснабжения органов и тканей. В ответ
усиливается активация эндокринных
адаптационных систем и развивается
артериальный спазм.
Значительно повышается функция
надпочечников. Уровень адреналина в плазме
повышается в 50-100 раз. Такая резкая
стимуляция бета-рецепторов усиливает
сократительную функцию миокарда и учащает
сердечную деятельность. Уровень
норадреналина возрастает в 5-10 раз.
97
98.
В первую очередь происходит спазмартериальных сосудов кожи и почек. Пациент
становится бледным, у него холодеют руки и
ноги, снижается мочеотделение, возрастает ЧСС,
но уровень АД остается нормальным.
Поскольку периферический ангиоспазм
неравномерен, происходит перераспределение
кровотока между различными зонами. Сосуды
сердца и мозга не отвечают выраженным
спазмом на кровопотерю и обеспечивают
кровью эти жизненно важные органы за счет
резкого ограничения кровоснабжения других
органов и тканей. Развивается так называемая
централизация кровообращения.
Продолжающееся кровотечение в конце концов
исчерпывает все компенсаторные механизмы.
Сосудистая емкость не может быть больше
уменьшена вазоконстрикцией, а снижение
сердечного выброса не компенсируется
увеличением ЧСС.
98
99.
После потери 20-30% ОЦК начинает снижатьсясистемное АД. В этих условиях даже выраженная
вазоконстрикция и тахикардия уже не способны
компенсировать низкий СВ. Из этого следует, что
падение АД не является ранним признаком
кровопотери, а развивается лишь в состоянии
декомпенсации. Этот показатель посуществу
отражает не величину кровопотери, а степень
устойчивости пациента к кровопотере.
При падении систолического АД ниже уровня 80
мм. рт. ст. уже нарушается кровоснабжение мозга,
сердца и почек, развивается отек мозга, острая
сердечная и почечная недостаточность. Таким
образом, возникает непосредственная угроза для
жизни человека. Период такой гипотензии не
должен быть продолжительным, поскольку уже
через 12ч. развивается необратимый
геморрагический шок.
99
100.
Увеличение ОЦК (патогенез)Повышается секреция антидиуретического
гормона гипофиза и альдостерона, которые
увеличивают реабсорбцию воды в почечных
канальцах, благодаря чему выделение жидкости
через почки уменьшается и она сохраняется в
кровеносном русле.
В процесс включаются микроциркуляция и
транскапиллярный обмен. За счет привлечения в
сосудистое русло межтканевой жидкости
возрастает объем циркулирующей плазмы и
соответственно ОЦК, и в результате развивается
гемодилюция. При этом снижается уровень
гематокрита (Ht) и концентрация гемоглобина (НЬ)
в крови.
100
101.
Клиника кровопотериСлабость
Сонливость
Головокружение
«мушки» перед
глазами
Зевота
Чувство нехватки
воздуха
Беспокойство
тошнота
Бледность и
холодность кожи и
слизистых
Одышка
Тахикардия
Слабый и частый
пульс
Снижение АД
Заторможенность,
нарушение сознания
Снижение диуреза
101
102.
Местные симптомыДля наружного
кровотечения характерно
наличие раны.
По внешнему виду можно
определить характер
кровотечения
(артериальное, венозное,
капиллярное)
По количеству вытекшей
крови можно определить
объем кровопотери
102
103.
Внутрибрюшное кровотечение(гемоперитонеум)
Притупление в отлогих
местах живота
Симптом «Ванькивстаньки»
Симптом раздражения
брюшины
Ослабление
перистальтики
Нависание стенки прямой
кишки при ректальном
исследовании
103
104.
Кровотечение в плевральную полость(гемоторакс)
Одышка
Притупление перкуторного звука
Ослабление дыхания при аускультации
Отставание поврежденной половины грудной
клетки при акте дыхания
Вынужденное положение больного
104
105.
Специальные методы диагностикиДиагностические пункции;
Эндоскопия;
Ангиография;
УЗИ;
Рентгеновское исследование;
КТ;
МРТ
105
106.
Метод шарящего катетера и лапароскопия106
107.
Метод внутрипросветнойэндоскопии
1. Эзофагогастродуоденоскопия (ЭГДС)
2. Ректороманоскопия (RRS)
3. Колоноскопия (КС)
4. Бронхоскопия (БС)
107
108.
Рентгеноскопический методКровотечение из варикозно расширенных вен пищевода
108
109.
Определение степени кровопотери по удельномувесу крови, содержанию гемоглобина и
гематокриту
Степень
кровопотери
Удельный
вес
Гемоглобин,
г/л
Гематокрит,
%
легкая
(до 10% ОЦК)
1057-1054
120-100
44-40
средняя
(до 20% ОЦК)
1053-1050
99-85
39-32
тяжелая
(до 30% ОЦК)
1049-1044
84-70
31-23
массивная
(более 30%)
менее 1044
менее 70
менее 23
109
110.
Клинические симптомы при различнойстепени кровопотери
степень
кровопотери
клинические признаки
легкая (до 10% ОЦК)
отсутствуют
средняя (до 20% ОЦК)
Минимальная тахикардия, снижение АД,
признаки периферической
вазоконстрикции (бледные холодные
конечности)
тяжелая (до 30% ОЦК)
Тахикардия до 120 в минуту, АД ниже 100
мм.рт.ст., беспокойство, холодный пот,
бледность, цианоз, одышка, олигурия
массивная (более 30%)
Тахикардия более 120 в минуту, АД 60
мм.рт.ст. и ниже, часто не определяется.
Ступор, резкая бледность, анурия
110
111.
Геморрагический шокСтадии геморрагического шока:
I стадия – компенсированный обратимый шок – объем
кровопотери, который восполняется компенсаторноприспособительными возможностями организма
стадия – декомпенсированный обратимый шок –
глубокие расстройства кровообращения. Накопление
метаболитов в тканях, парез капиллярного русла,
децентрализация кровообращения
II
стадия
- необратимый геморрагический шок –
длятельная (более 12 часов) неуправляемая артериальная
гипотензия, неэффективность трансфузионной терапии,
полиорганная недостаточность
III
111
112.
Шоковый индекс(Алговера – Бурри)
ШИ = ps/АД систолическое, норма = 0,5
Увеличение ШИ на 0,1- кровопотеря 0,2л
Пример:
ШИ=1,0 – кровопотеря 1 л (20% ОЦК)
ШИ=1,5 – кровопотеря 1,5 л (30% ОЦК)
ШИ=2,0 – кровопотеря 2 л (40% ОЦК)
112
113.
Методы временной остановкикровотечений
Наложение давящей повязки
Возвышенное положение конечности
Максимальное сгибание конечности в
суставе
Пальцевое прижатие сосуда
Наложение кровоостанавливающего жгута
Эсмарха
Тугая тампонада раны
1. Наложение кровоостанавливающего
зажима
Зонд Блекмора при пищеводных
кровотечениях
Временное шунтирование сосудов
113
114.
Временная остановка кровотеченийТочки пальцевого
прижатия артерии
к кости
114
115.
Временная остановка кровотеченияМаксимальное сгибание конечности
115
116.
Наложениекровоостанавливающего
жгута
116
117.
Наложение кровоостанавливающих зажимов на сосуды117
118.
ОСТАНОВКА КРОВОТЕЧЕНИЯИЗ ВАРИКОЗНО РАСШИРЕННЫХ
ВЕН ПИЩЕВОДА С ПОМОЩЬЮ
ЗОНДА БЛЭКМОРА
118
119.
Методы окончательной остановкикровотечений
Механические (перевязка сосуда в ране или
на протяжении, прошивание сосуда в ране,
длительная тампонада ран, сосудистый шов,
сосудистая пластика)
Физические (электрокоагуляция,
криохирургия, лазерный скальпель)
Химические (хлористый кальций. дицинон,
адреналин, питуитрин,
эпсилонаминокапроновая кислота)
Биологические (гемостатическая губка,
фибри-новая пленка, «аллоплант», биоплант,
фибрино-ген, тахокомб, викасол, витамин К)
119
120.
120121.
Механическая остановка кровтотечения(лигирование сосуда)
Лигирование сосуда была предложена еще в I веке нашей эры. В
1800 г. были использованы для лигирования рассасывающиеся швы
из оленьей кожи и пергамента, а в 1881 г. - хромированный кетгут.
Есть сведения, что в 1911 г. использовались серебряные клипсы для
гемостаза.
Все лигатуры представляют чужеродный материал и их выбор
основан на характеристиках материалов и состоянии раны.
Нерассасывающиеся швы, такие как шелк и пролен, вызывают
меньшую реакцию тканей, чем рассасывающиеся материалы, такие
как кетгут, дексон, викрил, полисорб. Однако рассасывающиеся
материалы предпочтительнее использовать в инфицированной ране.
При этом предпочтение следует отдавать монофиламентным нитям
или нитям покрытым оболочкой. Присутствие нерассасывающихся
материалов в инфицированной ране может приводить к их
отторжению и образованию лигатурных свищей.
В настоящее время клипирование сосудов с использованием
различных инертных материалов широко используется в
эндоскопической хирургии и хирургии для остановки кровотечения из
труднодоступных зон.
121
122.
Микроволновый нож.Микроволны представляют собой вид
электромагнитной энергии. Их распространение
сопровождается выделением тепла.
Микроволновый нож — инструмент,
позволяющий концентрировать
высокоэнергетическое микроволновое поле
вокруг режущего края острия. Благодаря
поглощению микроволн тканями этот метод
обеспечивает глубокую коагуляцию тканей, что
особенно необходимо для остановки
паренхиматозного кровотечения при
манипуляциях на таких обильно
васкуляризованных органах, как печень, почки
и селезенка. Микроволновой нож
электробезопасен.
122
123.
Ультразвуковой ножУльтразвуковой нож. В этом приспособлении для рассечения тканей
используют энергию ультразвуковых волн. Повреждение окружающих
тканей минимальное. Наряду с рассечением тканей ультразвуковой
нож, производящий колебания с частотой 55 000 с-1, «запаивает»
кровоточащие сосуды. Операционное поле остается чистым,
поскольку обугливание незначительно. Практически нет дыма и
запаха. В коагуляционном режиме устройство создает значительно
более низкие температуры, чем электрокоагулятор, электронож и лазер. Кроме того, больной не соприкасается с электричеством.
Многофункциональные хирургические инструменты, основанные на
эффекте
ультразвука, одновременно
позволяют рассекать ткани и
прижигать кровоточащие сосуды. Ультразвуковой скальпель
обеспечивает эффективный
гемостаз при пересечении сосудов до 3 мм в диаметре без
123
использования клипс или лигатур.
124.
Аргоновый лучевой коагуляторАргоновый лучевой коагулятор.
Прибор, использующий
концентрированный пучок
ионизированного аргона (так
называемую аргоновую
плазму) для воздействия на
ткани электрического тока
высокой частоты без
непосредственного контакта.
Струя аргона - бесцветного
инертного газа, не имеющего
запаха, позволяет
коагулировать ткани на
обширных участках,
обеспечивает чистоту
операционного поля, снижает
травматизацию тканей и риск
контакта медперсонала с
кровью больного.
124
125.
ЛазерыЛазеры используют для
рассечения, испарения и
одновременной коагуляции
намеченного участка без
повреждения окружающих
тканей. Механизм действия
лазера заключается в
накоплении энергии в
кровоточащем сосуде и
стимуляции свертывания.
Использование лазера
сопровождается хорошим
гемостазом, что позволяет
применять его при
эндоскопических и открытых
хирургических
вмешательствах.
125
126.
Химические средства для остановкикровотечения
Локальное использование таких препаратов, как
эпинефрин и адреналин, вызывает вазоконстрикцию в
зоне повреждения, но длительное применение может
привести к их всасыванию, системным гипертензионным
эффектам и усилению кровотечения. Подобные
препараты используют на влажных поверхностях в зоне
слизистых, например при тонзиллэктомии или
эндоскопической остановке желудочно-кишечных
кровотечений.
Местные гемостатические средства обычно
используются для остановки кровотечений при операциях на паренхиматозных органах и их повреждениях,
а также для герметизации сосудистого шва.
Осуществлять гемостаз при повреждении крупных
артерий и вен без их дотирования или ушивания дефекта
стенки невозможно. Важно также помнить, что
использование местных гемостатических средств не
заменяет тщательной хирургической техники и
грамотного использования специального
гемостатического инструментария.
126
127.
Биологические средства для остановкикровотечения
Для остановки кровотечения из открытых ран
эффективно используется местное применение
средств, которые обладают адгезивными
свойствами и закрывают раневую поверхность
или местно стимулируют свертывание и
вызывают вазоконстрикцию.
Исторически скелетная мышца была одним из
первых материалов с локальным
гемостатическим эффектом и была предложена
Cushing в 1911 г. Затем был разработан целый ряд
рассасывающихся препаратов для местной
остановки кровотечения, в том числе и
фибриновый клей, который изготавливается из
фибриногена и тромбина.
127
128.
Одним из самых надежныхсовременных средств для
остановки кровотечения во
время хирургической
операции является препарат
"ТахоКомб". Он состоит из
коллагеновой пластины,
покрытой с одной стороны
фибриногеном, тромбином,
апротинином и
рибофлавином. При контакте
с кровоточащей
поверхностью содержащиеся
в покрывающем слое
факторы свертывания
активируются, и тромбин
превращает фибриноген в
фибрин, что приводит к
образованию фибринового
сгустка. Пластина
"ТахоКомб" постепенно
рассасывается и в течение 36 нед замещается
соединительной тканью.
128
129.
Лекарственные препараты,влияющие на систему гемостаза
Ускоряющие
свертывание крови свежезамороженная
плазма,
криопреципитат и
отдельные факторы
свертывания.
Витамин К и его
синтетические аналоги
(но он действует очень
медленно),
Десмопрессин.
Угнетающие фибринолиз
- ингибиторы
фибринолиза,
аминокапроновая и
транексамовая
кислоты, апротинин
(трасилол).
129
130.
Восполнение кровопотериИнфузионно-трансфузионная терапия(ИТТ)
острой кровопотери преследует две
главные задачи –
устранение гиповолемии и
улучшение кислородно-транспортной
функции крови больного.
Для восполнения кровопотери
используют комбинацию коллоидных
и кристаллоидных растворов
130
131.
Противошоковые препаратыВолемические
Реологические
Полиглюкин
Реополиглюкин
Желатиноль
Реоглюман
Полиоксид
Поливисолин
Плазма
Альбумин
Волекам
Полиглюсоль
Полифер
131
132.
Компоненты ИТТДетоксицирующие
Кристаллоиды
Парентеральное
питание
Гемодез
Гемодез-Н
Поливисолин
Физ. раствор
Лактосол
Мафусол
Трисоль
Полиамины
Глюкоза
Жировые
эмульсии
132
133.
Восполнение кровопотериОптимальными стартовыми растворами должны
быть коллоидные растворы. Они более
длительно циркулируют в сосудистом русле,
поддерживают онкотическое давление плазмы и
тем самым удерживают жидкость в кровеносном
русле. В качестве коллоидных
кровезамещающих растворов до сих пор широко
используют свежезамороженную плазму,
препараты альбумина, растворы желатина,
декстранов и препараты
гидроксиэтилированного крахмала. Однако не
все препараты этой группы в равной степени
отвечают требованиям медикотактической
обстановки и патогенетическим концепциям.
133
134.
По традиции свежезамороженная плазма (СЗП) досих пор используется как источник коллоидов. Но на
сегодняшний день переливание СЗП представляет
большую опасность для реципиента, так как она может
быть контаминирована вирусами гепатита, а также
вирусом иммунодефицита человека. Аллергические и
анафилактические реакции, возможные острые
поражения легких и почек, иммунодефицитные
состояния и другие дополняют картину. Поэтому
Национальный институт здравоохранения США не
рекомендует использовать плазму в качестве
коллоидного кровезаменителя. Разумной
альтернативой плазме могут служить растворы 5 %
альбумина и гидроксиэтилированного крахмала (ГЭК).
134
135.
Восполнение кровопотериКоллоидные растворы на основе ГЭК, особенно их второго
поколения (в частности препарата Инфукол ГЭК 6% и 10%)
безопасны в безопасности применении в связи с низкой
частотой возникновения побочных реакций. Растворы этой
группы снижают проницаемость эндотелиальной стенки
капиллярных сосудов, улучшают реологические свойства
крови, их отличает стойкий волемический эффект, быстрый
метаболизм, а также значительно меньшее влияние на функцию
почек. Устранение острой гиповолемии растворами ГЭК
приводит к быстрой нормализации центральной гемодинамики,
микроциркуляции и транспорта кислорода, что в конечном итоге
нормализует биоэнергетические процессы на клеточном уровне.
Препараты ГЭК не влияют на систему свертывания крови.
Накопленный на сегодняшний день опыт
применения плазмозамещающих растворов
позволяют рекомендовать использование
растворов ГЭК как препаратов первого
выбора при возмещении острой
кровопотери.
135
136.
Расчет замещения кровопотериДля адекватного замещения кровопотери
переливают растворов 170 – 180% от ее
объема, при этом 50% объема инфузии
приходится на кровь и (или) ее
компоненты
136
137.
Компоненты крови для ИТТЭритромасса
Эритровзвесь
Тромбоцитарная масса
Гипериммунная плазма
Размороженные
эритроциты
Плазма
свежезамороженная
137
138.
Инфузионно-трансфузионная терапия при остройкровопотере
Кровопотеря Кровопотеря Кровопотеря
I cт (<650 мл) II cт (650-1000 III cт (10002000 мл)
мл)
Кровопотеря
IVcт (> 2000
мл)
Рефортан
650
мл
650 -1000
мл
1000 - 2000
мл
1500
мл
Кристаллоиды
500
мл
1000
мл
1000 -1500
мл
1500 2000 мл
СЗП
-
-
250 - 500
мл
500 - 1000
мл
250 - 500
мл
500 -1500
мл
Эритроцитар.
масса
138
139.
Трансфузия СЗП может быть замененавведением плазматических факторов
свертывания крови
Трансфузия эритроцитарной массы
показана при снижении показателя
Hb<80 г/л, Ht<25%
Показания для переливания
тромбоцитарной массы - уменьшение
количества тромбоцитов < 70х103 /мл
139
140.
Осложнения кровотечения икровопотери
Геморрагический шок
Ишемия органов, лишенных
кровоснабжения
Формирование ложных аневризм
Формирование ложных кист
Сдавление органов(головного мозга,
сердца, легких и т.д.)
Инфицирование гематом
140
141.
БЛАГОДАРЮ ЗАВНИМАНИЕ!!!
06.12.2022 14:13
141

Медицина
Медицина








